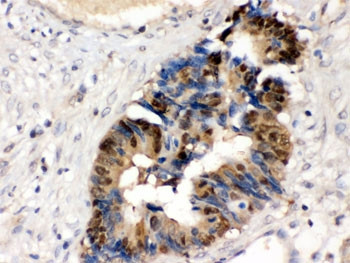
Anti-HINT1

Cookie-Einstellungen
Diese Website benutzt Cookies, die für den technischen Betrieb der Website erforderlich sind und stets gesetzt werden. Andere Cookies, die den Komfort bei Benutzung dieser Website erhöhen, der Direktwerbung dienen oder die Interaktion mit anderen Websites und sozialen Netzwerken vereinfachen sollen, werden nur mit Ihrer Zustimmung gesetzt.
Konfiguration
Technisch erforderlich
Diese Cookies sind für die Grundfunktionen des Shops notwendig.
"Alle Cookies ablehnen" Cookie
"Alle Cookies annehmen" Cookie
Ausgewählter Shop
CSRF-Token
Cookie-Einstellungen
FACT-Finder Tracking
Individuelle Preise
Kundenspezifisches Caching
Session
Währungswechsel
Komfortfunktionen
Diese Cookies werden genutzt um das Einkaufserlebnis noch ansprechender zu gestalten, beispielsweise für die Wiedererkennung des Besuchers.
Facebook-Seite in der rechten Blog - Sidebar anzeigen
Merkzettel
Statistik & Tracking
Endgeräteerkennung
Kauf- und Surfverhalten mit Google Tag Manager
Partnerprogramm
| Artikelnummer | Größe | Datenblatt | Manual | SDB | Lieferzeit | Menge | Preis |
|---|---|---|---|---|---|---|---|
| ARG58031.50 | 50 µg | - | - |
6 - 14 Werktage* |
559,00 €
|
Bei Fragen nutzen Sie gerne unser Kontaktformular.
Bestellen Sie auch per E-Mail: info@biomol.com
Größere Menge gewünscht? Bulk-Anfrage
Bestellen Sie auch per E-Mail: info@biomol.com
Größere Menge gewünscht? Bulk-Anfrage
Protein function: Hydrolyzes purine nucleotide phosphoramidates with a single phosphate group,... mehr
Produktinformationen "Anti-HINT1"
Protein function: Hydrolyzes purine nucleotide phosphoramidates with a single phosphate group, including adenosine 5'monophosphoramidate (AMP-NH2), adenosine 5'monophosphomorpholidate (AMP-morpholidate) and guanosine 5'monophosphomorpholidate (GMP-morpholidate). Hydrolyzes lysyl-AMP (AMP-N-epsilon-(N-alpha-acetyl lysine methyl ester)) generated by lysine tRNA ligase, as well as Met-AMP, His- AMP and Asp-AMP, lysyl-GMP (GMP-N-epsilon-(N-alpha-acetyl lysine methyl ester)) and AMP-N-alanine methyl ester. Can also convert adenosine 5'-O-phosphorothioate and guanosine 5'-O- phosphorothioate to the corresponding nucleoside 5'-O-phosphates with concomitant release of hydrogen sulfide. In addition, functions as scaffolding protein that modulates transcriptional activation by the LEF1/TCF1-CTNNB1 complex and by the complex formed with MITF and CTNNB1. Modulates p53/TP53 levels and p53/TP53-mediated apoptosis. Modulates proteasomal degradation of target proteins by the SCF (SKP2-CUL1-F-box protein) E3 ubiquitin- protein ligase complex. [The UniProt Consortium]
| Schlagworte: | Anti-HINT, Anti-HINT1, Anti-PKCI-1, EC=3.-.-.-, Anti-Protein kinase C inhibitor 1, Anti-Adenosine 5'-monophosphoramidase, Anti-Protein kinase C-interacting protein 1, Anti-Histidine triad nucleotide-binding protein 1 |
| Hersteller: | Arigo Biolaboratories |
| Hersteller-Nr: | ARG58031 |
Eigenschaften
| Anwendung: | IHC (paraffin), WB |
| Antikörper-Typ: | Polyclonal |
| Konjugat: | No |
| Wirt: | Rabbit |
| Spezies-Reaktivität: | human, mouse, rat |
| Immunogen: | Synthetic peptide from Human HINT1. (HISQISVAEDDDESLLGHLMIVGKKCAADLGLNK) |
| MW: | 14 kD |
| Format: | Antigen Affinity Purified |
Datenbank Information
| KEGG ID : | K02503 | Passende Produkte |
| UniProt ID : | P49773 | Passende Produkte |
| Gene ID : | GeneID 3094 | Passende Produkte |
Handhabung & Sicherheit
| Lagerung: | -20°C |
| Versand: | +4°C (International: +4°C) |
Achtung
Nur für Forschungszwecke und Laboruntersuchungen: Nicht für die Anwendung im oder am Menschen!
Nur für Forschungszwecke und Laboruntersuchungen: Nicht für die Anwendung im oder am Menschen!
Hier folgen Informationen zur Produktreferenz.
mehr
Hier kriegen Sie ein Zertifikat
Loggen Sie sich ein oder registrieren Sie sich, um Analysenzertifikate anzufordern.
Bewertungen lesen, schreiben und diskutieren... mehr
Kundenbewertungen für "Anti-HINT1"
Bewertung schreiben
Loggen Sie sich ein oder registrieren Sie sich, um eine Produktbewertung abzugeben.
Zuletzt angesehen